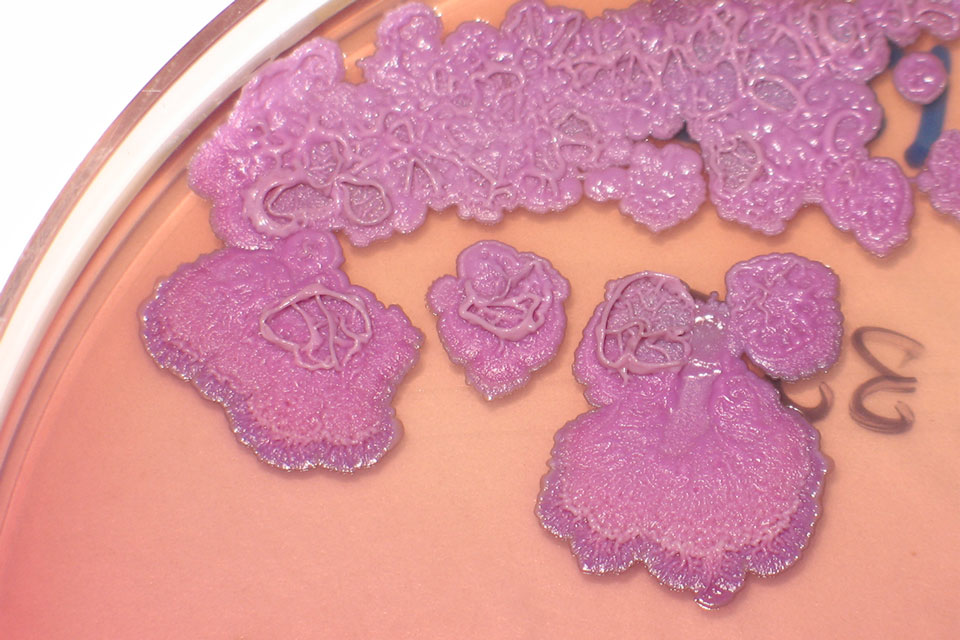
Burkholderia-pseudomallei-growing-on-agar-plates

‘The Great Mimicker’: meet the deadly bacterium spreading worldwide
Melioidosis has now been detected in almost every state in India, is surging in Australia, is increasingly reported from Africa and was recently found in the US. What is this deadly disease and why is it so little-known?
- 29 October 2025
- 11 min read
- by Lakshmi Gopinathan

In the lush paddy fields of India, a deadly bacterium lurks.
In Madhya Pradesh, which has seen a recent increase in paddy cultivation, a 45-year-old diabetic farmer suffered for three months with fever, chills and significant weight loss. He did not respond to treatment with broad-spectrum antibiotics. Symptoms and laboratory tests closely resembled tuberculosis.
It was only after culturing a pus sample from the farmer that the culprit was found: Burkholderia pseudomallei.
The patient recovered rapidly with the correct antibiotic treatment. Without accurate diagnosis and timely treatment, the outcome could have been fatal.
Factfile: Melioidosis
- Pathogen name: Burkholderia pseudomallei
- Pathogen type: Bacterium
- Source: Contaminated soil and water
- Infection route: Through skin cuts, inhalation of contaminated dust or water droplets, ingestion of contaminated food or water
- Symptoms: Highly variable, but include cough, fever, body aches, respiratory distress, fatigue weight loss and skin lesions. Disseminated sepsis is a severe and potentially fatal manifestation.
- Treatment: Fully treatable with antibiotics if diagnosed early
- High-risk populations: People with chronic diseases such as diabetes, kidney or liver disease. People with chronic alcohol abuse.
- Mortality rate: Variable, 10–50%. Under 10% in well-resourced settings such as Northern Australia.
- Annual cases: Estimated to be around 165,000; likely much higher due to underreporting.
- Annual deaths: Estimated to be around 90,000; likely higher due to underreporting.
- Geographical range: Southeast Asia, Northern Australia, South Asia. Recent detection in Africa, the Americas.
- Vaccine available: No
A deadly mimicker
B. pseudomallei causes melioidosis, a little-known, life-threatening disease with a wide array of symptoms.
Melioidosis, labelled ‘The Great Mimicker’, can easily be mistaken for other diseases. It can present as respiratory distress, pneumonia, skin and deep organ abscesses, urinary tract infection, osteomyelitis or septic arthritis.
“Two decades ago, the disease was virtually unknown in India – often undiagnosed or misdiagnosed as tuberculosis, sepsis of unknown origin or other tropical bacterial infections”, says Chiranjay Mukhopadhyay, Director, Manipal Institute of Virology and Professor in the Department of Microbiology, Kasturba Medical College in Manipal, India.
Pneumonia is a common presentation and in South Asia, where the burden of pulmonary tuberculosis is high, melioidosis is often misdiagnosed and treated as tuberculosis.
B. pseudomallei thrives in moist soils and natural waters of warm and humid climates. When people come in close contact with the contaminated soil or water, infection occurs through skin abrasions, inhalation of dust or water droplets, or drinking contaminated water.
“The combination of heavy monsoon rainfall, vast agricultural landscapes, a large population engaged in farming and fishing, common practices such as working barefoot or barehanded in soil and water, as well as traditional rituals involving close contact with wet soil, facilitate exposure to Burkholderia pseudomallei in India,” explains Mukhopadhyay.
Chronic diseases such as diabetes, liver or kidney disease that affect immune responses increase both the risk of infection with B. pseudomallei and severe outcomes.
“There is a huge expansion in the prevalence of diseases that predispose people to becoming sick when exposed to B. pseudomallei, of which diabetes mellitus is a major issue in South Asia,” says David Dance, Honorary Professor at The London School of Hygiene and Tropical Medicine, who spent much of his career working on melioidosis in Laos and Thailand.
Where is melioidosis found?
Melioidosis is endemic to tropical and subtropical regions such as southeast Asia and northern Australia.
Dance says that the disease is estimated to kill 90,000 people per year, yet “it does not strike fear into people’s hearts as it does not cause explosive outbreaks, like plague or COVID. For reasons we do not fully understand, it does not spread from person to person”. Recognition of this global disease as a major public health threat is essential, but lacking.
Recent years have seen the disease detected in parts of South Asia, Africa and the Americas. “Climate change and increasing foreign trade and travel may be spreading the bacterium to newer pastures,” notes Dance.
However, detection in new areas may not always reflect a true ‘spread’ and may instead reflect improved diagnostics and growing awareness, leading to recognition “in places where it has almost certainly been present but unrecognised for many years, or even centuries”, he adds.
Bart Currie, Professor and Leader of the Tropical and Emerging Infectious Diseases team at Menzies School of Health Research in Darwin, Australia, cites the recent recognition of melioidosis as endemic in a number of African countries as an example of “simply unmasking of a bacterium already present but hitherto not recognised”.
Currie describes recent cases in Mississippi, USA – the first time that the bacterium was acquired from the environment in continental USA – as an example of “a receptive location being newly established as endemic for melioidosis”.
Melioidosis numbers continue to increase, particularly in endemic countries.
In a recent article, Currie said he expected cases across northern Australia to further increase, driven by an increasing number of people living with diabetes, an ageing population, climate change and environmental disturbances as Australia develops its northern region.

Neglect takes lives
Mukhopadhyay recounts heartbreaking stories about the lives that could have been saved with timely diagnosis and treatment: “I still remember an 18-year-old boy, the only child of his parents, full of dreams and about to begin his engineering studies.
“He suddenly developed neurological symptoms and was later diagnosed with neuromelioidosis. Despite our best efforts, we lost him.
Have you read?
“In another case, an 11-month-old baby girl succumbed to septicaemic melioidosis before she could even take her first steps.
“A retired schoolteacher was misdiagnosed and treated for months with anti-tuberculosis drugs, only to die later from what was actually melioidosis.
“Then there was a young man who nearly drowned while performing his father’s last rites in a river and later developed aspiration pneumonia due to melioidosis – another tragic loss.”
Melioidosis is not mandatorily notifiable to the health authorities in most endemic countries and, Dance notes, even when it is, the true burden is probably higher than reported as many cases remain unnotified, undetected or misdiagnosed.
This, combined with low awareness among health workers, creates “a vicious circle of neglect in which public health authorities think that the burden of melioidosis is low and therefore give it low priority”, he rues.
As with most diseases, the poor bear a disproportionately high burden.
Dance notes: “This is mainly a disease of the rural poor, who tend to be accorded low priority by health services and are the last people to have access to good diagnostics.”
Mukhopadhyay points to the lack of awareness, particularly in peripheral and rural healthcare settings where the disease burden is likely higher.
Breaking the cycle of neglect
A trinity of awareness, diagnostics and surveillance is essential to manage melioidosis.
At the time of being interviewed for this feature, Mukhopadhyay was in Turakapalem, India, investigating a suspected melioidosis outbreak and training regional laboratories in diagnosis and environmental surveillance.
“Limited governmental and institutional awareness has delayed the inclusion of melioidoisis in national disease frameworks, but as awareness spreads, we expect to detect more cases – with better preparedness and hope for survival,” he says.
Educational campaigns for both the public and healthcare workers about the disease, its myriad symptoms and sources will aid in prevention (by avoiding exposure) and early diagnosis.
Dance emphasises the need for “better, sensitive and affordable diagnostics, as the existing gold standard of growing the bacterium and identifying it is slow and requires considerable resource and expertise.”
“Support for improved microbiology resources is crucial, especially the ability to perform blood cultures,” notes Currie, adding that over 50% of melioidosis cases test positive in blood cultures.
Efforts must focus on the poor and “access for all to the diagnostics and the expensive specific antibiotics required for therapy”, Currie opines.
He adds that, while resources may be lacking in endemic regions, “even in developed countries, diagnosis can be delayed or missed because melioidosis is not thought of or because the laboratory may not have experience with B. pseudomallei.
“In the USA, recently, automated systems resulted in misidentification of B. pseudomallei as another bacterium, potentially delaying effective therapy.”
To know where the bacterium is and how many people it is infecting – the true burden – surveillance needs to be expanded globally, notes Dance. This requires “continuing to work on better defining endemic regions globally and regionally or within counties,” concurs Currie.
Is there a vaccine for melioidosis?
In a post-COVID-19 world that saw immunisation act as a crucial weapon against a new virus, vaccines seem like one potential beacon of hope in the fight against yet another emerging pathogen.
There is no vaccine for melioidosis yet, although several research groups are actively working towards their development, particularly for people with chronic diseases and the elderly, who are both at increased risk.
Dance, however, is not pinning all his hopes on a vaccine. “Personally I have never been very optimistic about melioidosis vaccines, as this is most often a disease of reduced immune function.
“People such as rice farmers who are repeatedly exposed to B. pseudomallei in soil and water usually don’t become unwell until they develop a compromised immune system as a result of a disease like diabetes. Will vaccines be able to overcome this?”
He follows with cautious optimism: “Having said that, a number of excellent groups around the world are working to develop vaccines and, with newer technologies, who knows what may be possible.”
As many vaccine research programmes and trials are halted world-over due to funding cuts, Currie expresses hope, albeit for the long term: “There have been three decades of working together across country boundaries to achieve major advances in understanding melioidosis and moving towards a vaccine.”
“Colleagues in the USA have been an important part of these collaborations but currently some of them are furloughed. While much of the vaccine work has been put on hold because of withdrawal of funding, we should be hopeful that this will be taken up again in future years.
Hope amid adversity
Amid the neglect, researchers and health workers have tirelessly campaigned for melioidosis to be accorded the official status of a neglected tropical disease (NTD) by the World Health Organization (WHO).
In 2017, at the American Society of Microbiology Biothreats meeting, Dance said, “This is a disease so neglected, it’s missing from the WHO list of neglected diseases,” an oft-repeated quote that nearly a decade later still rings painfully true.
If melioidosis is included in the list, Dance believes that “it would encourage more endemic countries to give it the priority it deserves and develop national action plans.”
Currie is pragmatic: “The crises in funding for the WHO and other organisations in this current difficult period of decreasing support for global health agendas, suggest that we shouldn’t have unrealistic expectations of what the WHO can do even if it did list melioidosis as an NTD.”
Mukhopadhyay adds that the classification of B. pseudomallei by the US Centers for Disease Control and Prevention (CDC) as a Tier 1 select agent – posing the “greatest risk of deliberate misuse” – discourages open reporting as laboratory personnel are apprehensive about handling and documentation.
In addition, the US CDC classifies the bacterium as a category B bioterrorism agent. This is attributed to the potential for dissemination of the bacteria by air or water coupled with the potential severity of melioidosis. Burkholderia mallei , a close relative that causes glanders, has a history of deliberate use during World War I, before and during World War II.
Dance mentions that even B. pseudomallei's classification as a potential bioterrorism agent by the US CDC in 2002, which caused a surge of global interest in melioidosis and increased funding from the USA, is no longer enough for sustained interest. Although he never believed that B. pseudomallei was the most likely agent to be used by terrorists, this interest undoubtedly brought benefits for melioidosis as a real-world problem. “Sadly, this focus seems now to be reducing,” he says.
Nevertheless, Dance reflects on the considerable progress since he first started working on melioidosis in 1986. “At that time, the overall mortality in Thailand was around 45%, and in patients with the disseminated septicaemic form, it was 87%. Today, the overall mortality rate in Northern Australia is below 10%.”
Reflecting on India’s milestones, Mukhopadhyay speaks of the establishment of the Indian Melioidosis Research Forum in 2015 and The MISSION, Indian Council of Medical Research Task Force in 2022.
He adds that these have now engaged “more than 100 healthcare centres, leading to confirmed diagnoses of melioidosis from 23 states”.
He shares preliminary results from a study that analysed suspected melioidosis cases from healthcare facilities across 14 Indian states over a period of two and a half years. Of the 3,000 suspected cases, 8% were confirmed to be melioidosis: “a remarkable indicator of hidden disease burden,” he notes.
With such progress coming in the face of stark neglect, one can only imagine what a global commitment to combating this disease can achieve.
“The good news,” concludes Dance, “is that there is a fantastic, highly collaborative, international group of researchers who have dedicated their lives to combating this deadly disease, and who are only too willing to do all they can to help.”
More from Lakshmi Gopinathan
Recommended for you








